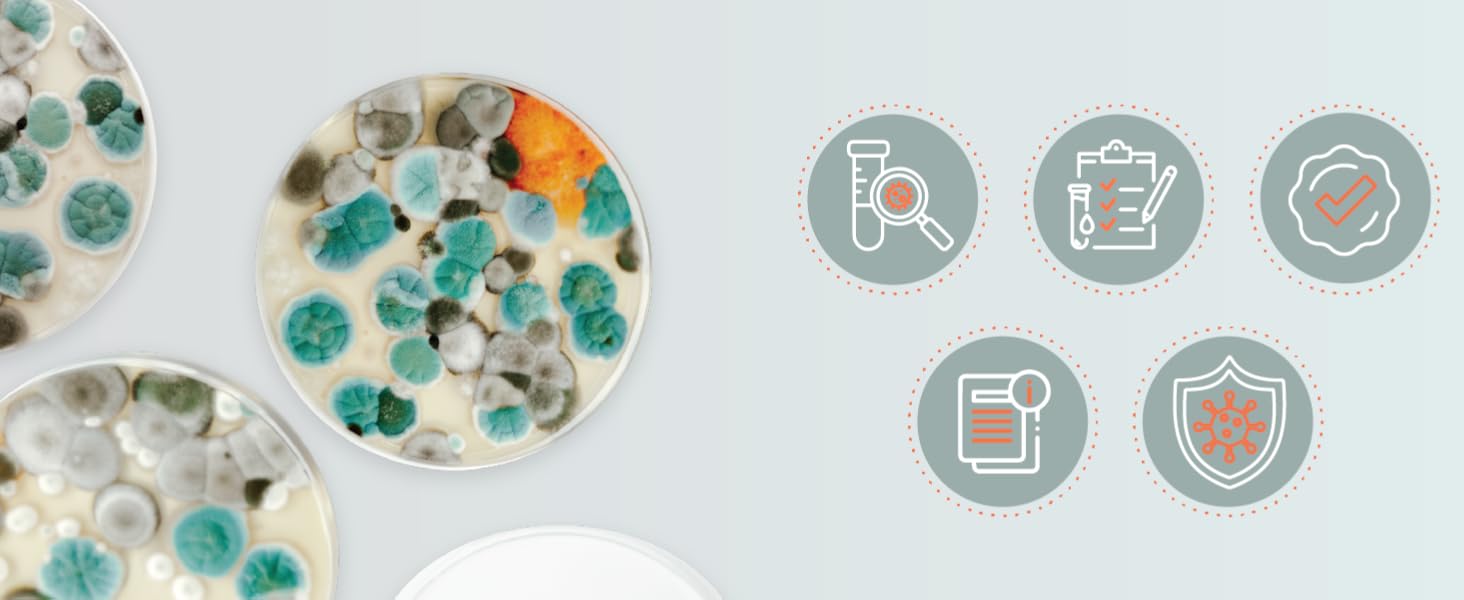
Mold Test Kit – Test 10 Different Areas, Swab Sample and Air Sample, Easy-to-Use Guide,-Testing
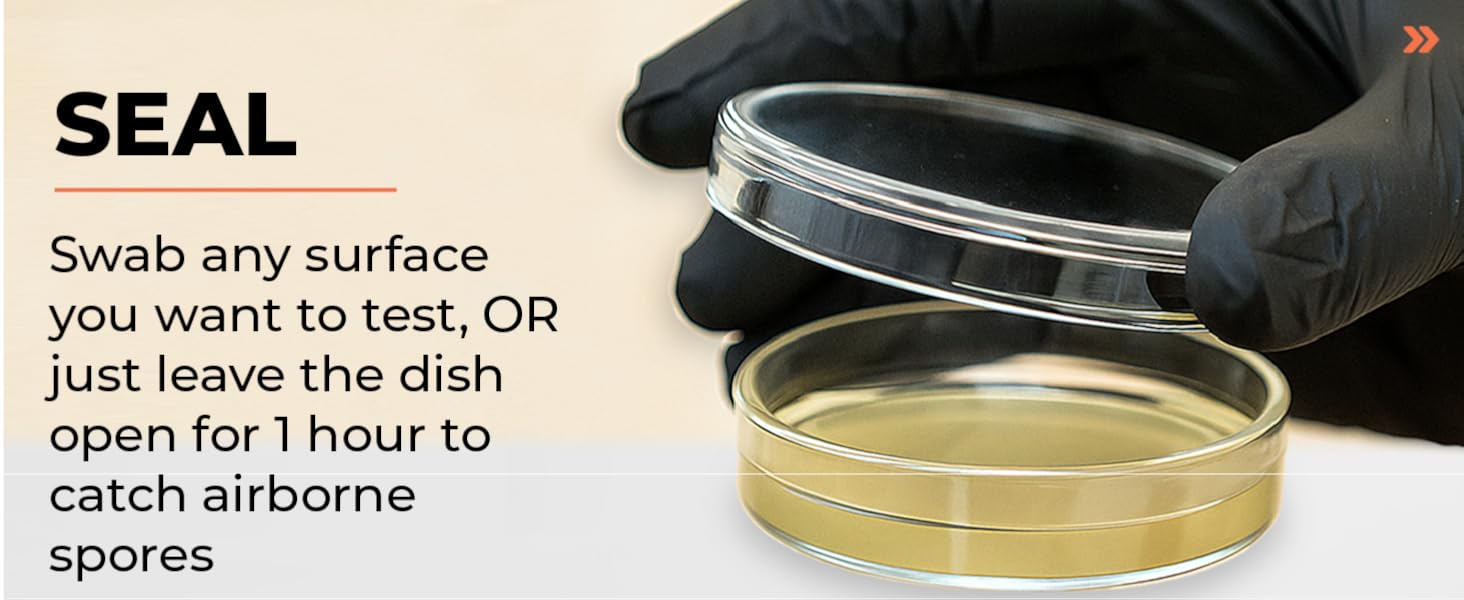
Mold Test Kit – Test 10 Different Areas, Swab Sample and Air Sample, Easy-to-Use Guide,-Testing
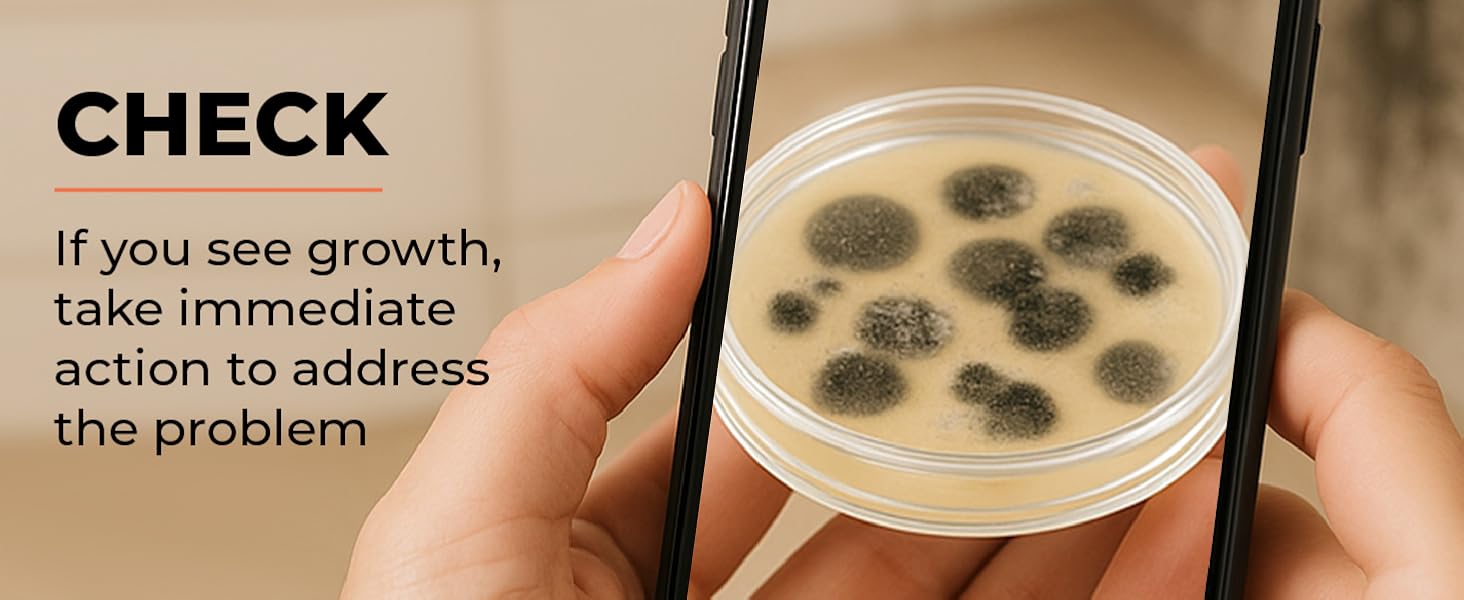
Mold Test Kit – Test 10 Different Areas, Swab Sample and Air Sample, Easy-to-Use Guide,-Testing

- TikTok Shop
- Tools & Hardware
- Measuring Tools
- Physical Measuring Instruments
- Mold Test Kit – Test 10 Different Areas, Swab Sample and Air Sample, Easy-to-Use Guide,-Testing









About this product
$38.99
$9.99 shipping on this order
Mold Test Kit – Test 10 Different Areas, Swab Sample and Air Sample, Easy-to-Use Guide,-Testing
0 sold
Specification:Default
Default
Quantity:
Coupon center
Log in to check your coupons
View and claim any available offers once you're logged in.
Shipping & returns
Shipping & delivery
Many items qualify for free shipping or become eligible once the order threshold is met.
Returns made easy
Most items are eligible for free returns within 30 days of delivery for a refund. Some items, including ingestibles, hygiene products, and pre-owned goods, are non-returnable. Final sale items cannot be returned or replaced. Please log in to view this item's specific return policy.
About this shop

DailyUse LifeEssentials
6 Sold
Visit
Explore more from DailyUse LifeEssentials
You may also like![[medicube] Mix & Match Toner Pad Setㅣ Pore, Use After Spot, Brightening Care for Clear & Glass Glow SkinㅣTikTok Viral Toner Pads [medicube] Mix & Match Toner Pad Setㅣ Pore, Use After Spot, Brightening Care for Clear & Glass Glow SkinㅣTikTok Viral Toner Pads](https://p16-oec-general-useast5.ttcdn-us.com/tos-useast5-i-omjb5zjo8w-tx/888b71f6640b4b8fafdd44437e6ae6df~tplv-fhlh96nyum-crop-webp:300:300.webp?dr=12190&t=555f072d&ps=933b5bde&shp=8dbd94bf&shcp=607f11de&idc=useast5&from=2378011839)




















![[medicube] Mix & Match Toner Pad Setㅣ Pore, Use After Spot, Brightening Care for Clear & Glass Glow SkinㅣTikTok Viral Toner Pads [medicube] Mix & Match Toner Pad Setㅣ Pore, Use After Spot, Brightening Care for Clear & Glass Glow SkinㅣTikTok Viral Toner Pads](https://p16-oec-general-useast5.ttcdn-us.com/tos-useast5-i-omjb5zjo8w-tx/888b71f6640b4b8fafdd44437e6ae6df~tplv-fhlh96nyum-crop-webp:300:300.webp?dr=12190&t=555f072d&ps=933b5bde&shp=8dbd94bf&shcp=607f11de&idc=useast5&from=2378011839)
medicube US Store

4.7
113.4K sold
-40%$36.90$62.00




Bask and Lather Co

4.7
10.2K sold
-45%$20.34$36.99



SweetSweat

4.5
876 sold
-24%$48.45$63.90

5.0
859 sold
-34%$13.20$19.97




BYLT Basics

4.9
1.1K sold
-10%$49.50$55.00

![[Mothersday]Steam Mop 12-in-1 Floor Cleaner with Detachable Handheld Steamer for Walls, Grout, Floors, Tiles, Carpets & Grease. Includes Multi-Function Accessories Cleaning Tools Cleaning Set [Mothersday]Steam Mop 12-in-1 Floor Cleaner with Detachable Handheld Steamer for Walls, Grout, Floors, Tiles, Carpets & Grease. Includes Multi-Function Accessories Cleaning Tools Cleaning Set](https://p16-oec-general-useast5.ttcdn-us.com/tos-useast5-i-omjb5zjo8w-tx/350e4adffa7c41dfa1b3abae0362bec2~tplv-fhlh96nyum-crop-webp:300:300.webp?dr=12190&t=555f072d&ps=933b5bde&shp=8dbd94bf&shcp=607f11de&idc=useast5&from=2378011839)

![[Mothersday]DEVOAC 10-in-1 Electric Steam Mop with Detachable Handheld Steamer Lightweight for Walls Floors,Tiles Tackles Grease&Sticky Messes,Steam Cleaner For House, Multi-Accessories Portable Cleaning [Mothersday]DEVOAC 10-in-1 Electric Steam Mop with Detachable Handheld Steamer Lightweight for Walls Floors,Tiles Tackles Grease&Sticky Messes,Steam Cleaner For House, Multi-Accessories Portable Cleaning](https://p16-oec-general-useast5.ttcdn-us.com/tos-useast5-i-omjb5zjo8w-tx/85f833ee6bef4b6ebc2ddfeeabaebdbf~tplv-fhlh96nyum-crop-webp:300:300.webp?dr=12190&t=555f072d&ps=933b5bde&shp=8dbd94bf&shcp=607f11de&idc=useast5&from=2378011839)
